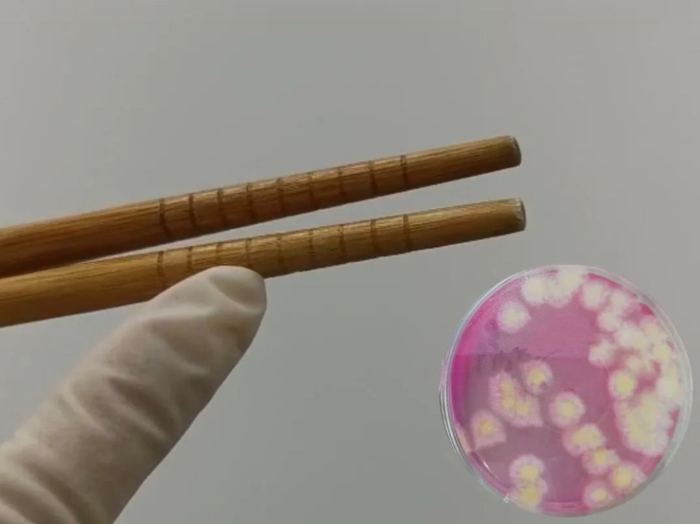

来源:腾讯医典
豆瓣网友@童童打灯:
我妈把不穿的衣服剪成一块块大小不等的布片,做抹布。有一次我在厨房发现一半胸罩,我立刻炸毛了:“你!你还能更有才一点吗?”我妈羞赧:“上面的花纹去油渍比普通抹布好。”
豆瓣网友@LesParasites:
我妈为了省几十块洗车费,总是手动洗车。天气太热,于是开着空调洗内厢,四格油洗成一格了……
对于老一辈来说,什么东西坏了都不能丢。新三年、旧三年,缝缝补补又三年,至于扎不扎脚,爸妈就管不着了。
 (图源:网络)
(图源:网络)“节省”虽然是中华民族的传统美德,但如果在一些不该省的地方节省,也有可能省出病,甚至省出癌症来……

厨房里有两样东西,常常被人忽略——筷子、菜板。
尤其是“服役”几年的菜板,划痕众多,外观明显变色,可妈妈却仍旧舍不得换。
“我每天都洗得干干净净的,怎么会脏?”
 (图源:网络)
(图源:网络)家里用了几年的菜板、筷子,真的像表面上那么干净吗?
2020年,深圳市消费者委员会检测了36块使用过的实木菜板、竹菜板、塑料菜板,结果发现:
用了2年以上的菜板,在菌落总数、霉菌和大肠菌群数方面,比使用不到2年的明显更多[1]。
所以,建议菜板用后及时清洗晾干,视情况2年左右更换新的。

▲数据来自深圳消费者委员会官网
(由于样本量有限,仅供参考)
而网传“筷子3个月就要换新,否则容易滋生大量细菌”,是真的吗?
2020年,上海消保委征集了200双普通家庭用过的旧筷子,测试发现:
使用时间超过6个月的筷子,霉菌数量比新筷子和3个月的筷子要多30%以上[2]。
尤其是竹木筷更易发霉,旧筷子表面细小的凹槽也更易残留细菌。
(图源:上海消保委官网)
(图源:上海消保委官网)请告诉爸妈:
筷子、菜板用完后,要及时用流水清洗干净,并晾干水分保持通风干燥,定期消毒。
菜板建议2年左右更换,筷子半年左右更换。

老一辈人好像都不舍得开电器,怕费电。
晚上在客厅,有人总是把灯关了,就开着电视;
炒菜也不舍得开抽油烟机,还怼儿女说以前都没用过不也照样好好的!
 (图源:soogif)
(图源:soogif)但长期这样“节省”,可能会对身体造成一定影响。
1、长期不开灯看电视
关灯看电视时,屏幕上的亮光强弱变换和闪烁,会强烈刺激眼睛,眼睛容易疲劳,时间长了可能会影响视力。
另一方面,在昏暗中玩电子产品或看电视时,为了适应暗的环境,眼睛的瞳孔会放大,如果有房角先天狭窄因素的,由于瞳孔放大,眼球内的“房水”循环受阻,有可能会导致眼压升高。
“房水”是一种协助维持眼压、为眼角膜和晶状体提供营养的透明液体。
长期的高眼压,可能压迫视网膜和视神经,增加患青光眼的风险。如果不及时治疗,最后甚至会失明。
2、炒菜不开抽油烟机
在我国,肺癌是女性第二高发的癌症[3]。
一项汇总研究发现,做菜时的油烟中含有多种强致癌物质如苯并芘、多环芳烃等物质,长时间吸入烹饪油烟的女性,发生肺癌的风险与不接触厨房油烟的女性相比,提高了1.94倍[4]。
同时,长期吸入大量油烟,还会刺激呼吸系统,特别是原本就有呼吸系统疾病的人,病情有可能加重[5]。
 (图源:soogif)
(图源:soogif)请告诉爸妈:
看电视时最好留一盏照明灯,使用电子产品时也一样。
做饭时要及时打开抽油烟机,并且定期清洁抽油烟机。


肥皂是家里的必备清洁用品,用久了只剩最后一点的时候,很多人习惯攒起来重塑成一块大的,就像这样:
 (图源:知乎)
(图源:知乎)看起来很有勤俭持家典范那味……
但实际上,用这样的肥皂头洗手或者洗衣服,可能达不到清洁杀菌的效果,甚至可能越洗越脏!
因为制造肥皂的主要原料油脂,在一定的温度、湿度下特别容易酸败(颜色变深变黄),产生酸、醛、酮类以及各种氧化物。
此时的肥皂,不但去污能力下降,还会成为细菌滋生的“优良培养基”,通过洗手、洗衣服,将细菌带到人身上[6]。
快告诉爸妈,这类攒久了发黄的肥皂头,就别再用啦!
 (图源:soogif)
(图源:soogif)
对于家里节省的长辈来说,矿泉水瓶、饮料瓶等简直是宝贝!
进可循环利用,装油装水装一切,退可用来养花种蒜栽棵葱,再不济还能攒起来卖废品……
 (图源:羊城晚报)
(图源:羊城晚报)
但是网络上一直有个传言:
矿泉水、饮料瓶不能用来装油、酒和粮食,也不能重复用来装热水,否则会析出可能致癌的DEHP(邻苯二甲酸酯,一种增塑剂),是真的吗?
 (图源:soogif)
(图源:soogif)我们生活中常见的塑料,一般会用3个箭头组成的环形三角形表示“可回收利用”,中间的阿拉伯数字则代表塑料种类。

(常见的塑料种类)
常见的矿泉水瓶、饮料瓶,一般是1号塑料PET(聚对苯二甲酸乙二醇酯),也有一些是4号塑料PE。
而我国GB9685-2016《食品接触材料及制品用添加剂使用标准》明确规定,DEHP在塑料中的适用范围仅限于PVC(聚氯乙烯)材料,也就是3号塑料,其他材料不适用[7]。
矿泉水瓶等塑料制品,不需要塑化剂DEHP来“画蛇添足”增塑。
也就是说,正规合格的1号塑料瓶,制作过程并不会使用DEHP。
那矿泉水瓶就可以反复一直用了吗?
非也。主要原因有两个:
1. 不排除以下小概率事件导致矿泉水瓶中含有DEHP:
有研究表明,PET塑料使用10个月后,可能释放出DEHP[8]。当然,释放出的DEHP毒性其实很微小,大家也不用太担心。
2. 矿泉水瓶、饮料瓶反复使用,很难保证卫生。
矿泉水、饮料在生产时,瓶子肯定是消过毒的,但被重复使用时,我们并不能做到合格消毒,能洗洗就不错了,所以瓶子卫生无法保证。
对老一辈人的节俭
我们可以多一些理解
但有害健康的节省习惯
也要及时纠正
重要的是多关心关心长辈
教他们熟悉现代化产品
掌握科学、健康的节省方式
 (图源:soogif)
(图源:soogif)审核专家:
付彦芬 | 中国疾病预防控制中心农村环境卫生检测室主任
郭纯刚 | 北京佑安医院眼科主任
刘海舰 | 中国科学院大学宁波华美医院呼吸内科主治医师
张 泓 | 国家食品安全风险评估中心助理研究员
参考文献
[1]深圳市消费者委员会.2020年砧板比较试验报告.2020-10-27.
http://www.sz315.org/html/show-57-9141.html
[2]上海市消费者权益保护委员会.筷子易发霉?怎样消毒更有效?我们帮您测试好了.2020.10.22.
https://315.sh.cn/html/bjsy/2020/10/26/0952fdd4-4d2d-42d8-a253-90f5639d376a.shtml
[3]李博, 王安辉. 女性肺癌危险因素研究进展[J]. 医学综述, 2019, v.25(18):81-86+91.
[4]奉水东, 凌宏艳, 陈锋. 烹调油烟与女性肺癌关系的Meta分析[J]. 环境与健康杂志, 2003, 20(006):353-354.
[5]厉曙光,黄昕. 家庭厨房烹调油烟污染的危害[J]. 上海预防医学2003.(2期):57-59.
[6]梁玉红, 周令, 熊帮洁,等. 医院洗手肥皂染菌状况调查与分析[J]. 医学动物防制, 2007, 23(004):259-260.
[7]GB 9685-2016.食品接触材料及制品用添加剂使用标准[S].
[8]Shanna H. Swan, Environmental phthalate exposure in relation to reproductive outcomes and other health endpoints in humans. Environmental Research Volume 108, Issue 2, October 2008, Pages 177-184.
文章评论